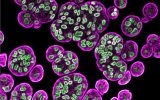

16 марта
15 марта
-
18:57
Найдена одинокая галактика, которая поглотила всех бывших спутников
 Космос
Космос
-
18:32
Названа главная опасность «нестабильных» лун для Вселенной
 Космос
Космос
-
17:15
Раскрыт секрет долголетия: ученые поняли, как запустить нужный механизм в теле человека
 Новости
Новости
-
16:38
Дюны странной формы нашли на Марсе. Ученые не знают, как они появились
 Космос
Космос
-
15:28
Найден клад, который спрятали во время войны почти 1 000 лет назад
 Наука
Наука
-
15:15
Названа новая причина возникновения аутизма
 Наука
Наука
14 марта
-
15:32
Опубликованы первые кадры с огромным айсбергом А81
 Наука
Наука
-
15:00
Войти в ИТ: кто такой UX-писатель и как научиться профессии
 Кейсы
Кейсы
-
14:24
Стартап запустит корабль на аммиаке к концу года
 Новости
Новости
-
13:35
Посмотрите на огромный мегакорабль. Он рекордсмен по перевозке грузов
 Новости
Новости
-
12:34
Назван пептид, который мог запустить жизнь на Земле
Наука
Наука
-
12:00
Почти 90% россиян не разбираются в ИТ-сфере: опрос
 Новости
Новости
-
11:52
Названа главная ошибка в лечении рака простаты
 Наука
Наука
-
10:57
Найдена гробница, которая защищала живых от «беспокойных мертвых»
 Наука
Наука
13 марта
-
19:09
ИИ извинился за вымирание человечества: в США появился памятник апокалипсису
 Новости
Новости
-
18:35
Мир океана нашли у маленькой, но опасной звезды
 Космос
Космос
-
17:52
Найдено самое древнее упоминание бога Одина. Оно «пряталось» в золотом кладе
 Наука
Наука


